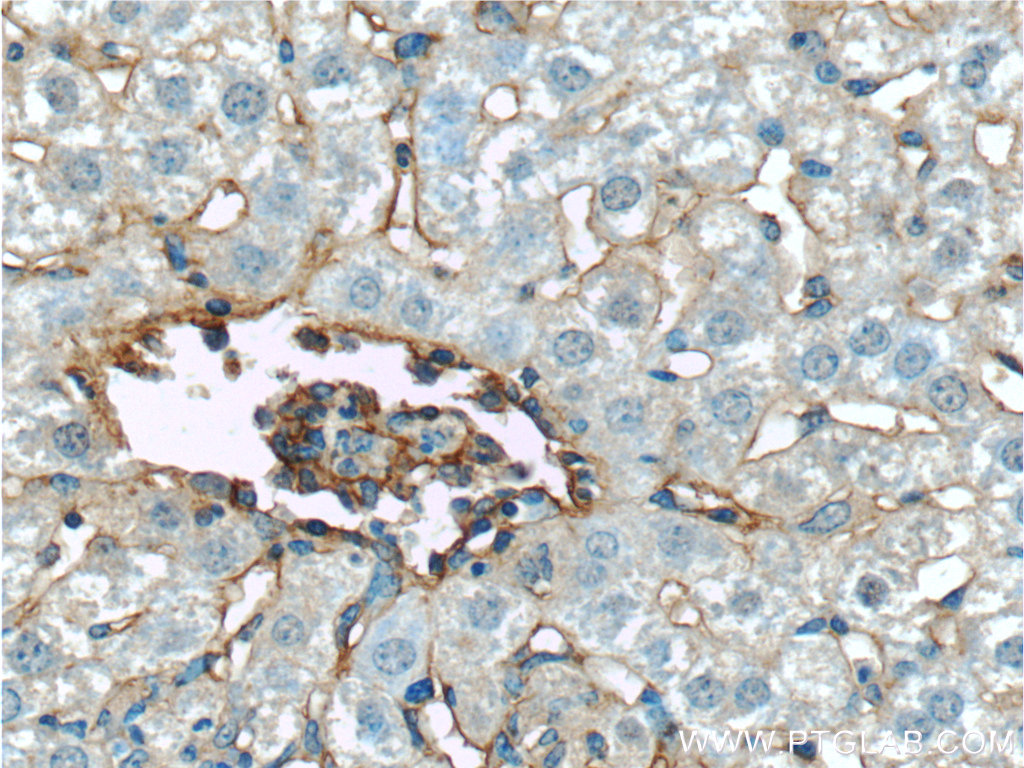

验证数据展示
经过测试的应用
| Positive WB detected in | mouse brain tissue, mouse spleen tissue, mouse liver tissue |
| Positive IHC detected in | mouse lung tissue, mouse liver tissue Note: suggested antigen retrieval with TE buffer pH 9.0; (*) Alternatively, antigen retrieval may be performed with citrate buffer pH 6.0 |
| Positive IF-P detected in | mouse liver tissue |
| Positive IF-Fro detected in | mouse liver tissue |
推荐稀释比
| 应用 | 推荐稀释比 |
|---|---|
| Western Blot (WB) | WB : 1:1000-1:4000 |
| Immunohistochemistry (IHC) | IHC : 1:3200-1:12800 |
| Immunofluorescence (IF)-P | IF-P : 1:500-1:2000 |
| Immunofluorescence (IF)-FRO | IF-FRO : 1:50-1:500 |
| It is recommended that this reagent should be titrated in each testing system to obtain optimal results. | |
| Sample-dependent, Check data in validation data gallery. | |
产品信息
10020-1-AP targets ICAM-1/CD54 in WB, IHC, IF-P, IF-Fro, ELISA applications and shows reactivity with mouse, rat samples.
| 经测试应用 | WB, IHC, IF-P, IF-Fro, ELISA Application Description |
| 文献引用应用 | WB, IHC, IF |
| 经测试反应性 | mouse, rat |
| 文献引用反应性 | mouse, rat, bovine, hamster |
| 免疫原 |
Peptide 种属同源性预测 |
| 宿主/亚型 | Rabbit / IgG |
| 抗体类别 | Polyclonal |
| 产品类型 | Antibody |
| 全称 | intercellular adhesion molecule 1 |
| 别名 | CD54, Icam-1, ICAM 1, Icam1, MALA-2 |
| 计算分子量 | 59 kDa |
| 观测分子量 | 95-100 kDa |
| GenBank蛋白编号 | NM_010493 |
| 基因名称 | ICAM-1 |
| Gene ID (NCBI) | 15894 |
| RRID | AB_2121773 |
| 偶联类型 | Unconjugated |
| 形式 | Liquid |
| 纯化方式 | Antigen affinity purification |
| UNIPROT ID | P13597 |
| 储存缓冲液 | PBS with 0.02% sodium azide and 50% glycerol, pH 7.3. |
| 储存条件 | Store at -20°C. Stable for one year after shipment. Aliquoting is unnecessary for -20oC storage. |
背景介绍
Where is ICAM-1 expressed?
Intercellular Adhesion Molecule 1 (ICAM-1), also known as Cluster of Differentiation 54 (CD54) is a transmembrane glycoprotein constitutively expressed at low levels in endothelial cells, pericytes and on some lymphocytes and monocytes1. It is located at the cytoplasmic membrane, with a large extracellular region of mainly hydrophobic amino acids joined to a small transmembrane region and a cytoplasmic tail. It has a molecular weight of 60 to 115 kDa depending on the level of glycosylation.
What is the function of ICAM-1?
ICAM-1 is important in both innate and adaptive immune responses as an adhesion molecule. Although it is constitutively expressed, in the presence of pro-inflammatory cytokines such as TNFα the endothelial cells are activated and upregulate expression of ICAM-12. In blood vessels lined with endothelial cells, leukocytes that are rolling over the surface are able to bind to ICAM-1 and transmigrate through the endothelial barrier and into the tissue. The initial binding of the leukocytes to ICAM-1 causes a Ca2+ release that initiates endothelial cell contraction and weakening of the intercellular tight junctions3, 4. This protein can be used as an indicator of endothelial activation and of vascular inflammation.
What is the role of ICAM-1 in disease?
Beyond the role in the immune response, ICAM-1 has also been identified as the target of attachment for the human rhinovirus, the cause of the common cold. Binding of the virus to ICAM-1 causes the viral capsid to uncoat and leads to release of the genetic material5.
Hubbard, A. K. & Rothlein, R. Intercellular adhesion molecule-1 (ICAM-1) expression and cell signaling cascades. Free Radic. Biol. Med. 28, 1379-86 (2000).
Long, E. O. ICAM-1: getting a grip on leukocyte adhesion. J. Immunol. 186, 5021-3 (2011).
Lawson, C. & Wolf, S. ICAM-1 signaling in endothelial cells. (2009).
Lyck, R. & Enzmann, G. The physiological roles of ICAM-1 and ICAM-2 in neutrophil migration into tissues. Curr. Opin. Hematol. 22, 53-59 (2015).
Xing, L., Casasnovas, J. M. & Cheng, R. H. Structural analysis of human rhinovirus complexed with ICAM-1 reveals the dynamics of receptor-mediated virus uncoating. J. Virol. 77, 6101-7 (2003).
Bui, T. M., Wiesolek, H. L., & Sumagin, R. ICAM-1: A master regulator of cellular responses in inflammation, injury resolution, and tumorigenesis. Journal of leukocyte biology. 108(3), 787-799 (2020).
实验方案
| Product Specific Protocols | |
|---|---|
| IF protocol for ICAM-1/CD54 antibody 10020-1-AP | Download protocol |
| IHC protocol for ICAM-1/CD54 antibody 10020-1-AP | Download protocol |
| WB protocol for ICAM-1/CD54 antibody 10020-1-AP | Download protocol |
| Standard Protocols | |
|---|---|
| Click here to view our Standard Protocols |
发表文章
| Species | Application | Title |
|---|---|---|
Immunity Toll-like receptor 4 signaling by follicular dendritic cells is pivotal for germinal center onset and affinity maturation. | ||
Nature Mechanosensing by β1 integrin induces angiocrine signals for liver growth and survival. | ||
Gastroenterology ECM1 Prevents Activation of Transforming Growth Factor β, Hepatic Stellate Cells, and Fibrogenesis in Mice. | ||
Hepatology Angiocrine Wnt signaling controls liver growth and metabolic maturation in mice. | ||
Nat Commun Reducing Akt2 in retinal pigment epithelial cells causes a compensatory increase in Akt1 and attenuates diabetic retinopathy | ||
EBioMedicine Patient-derived melanoma organoid models facilitate the assessment of immunotherapies |